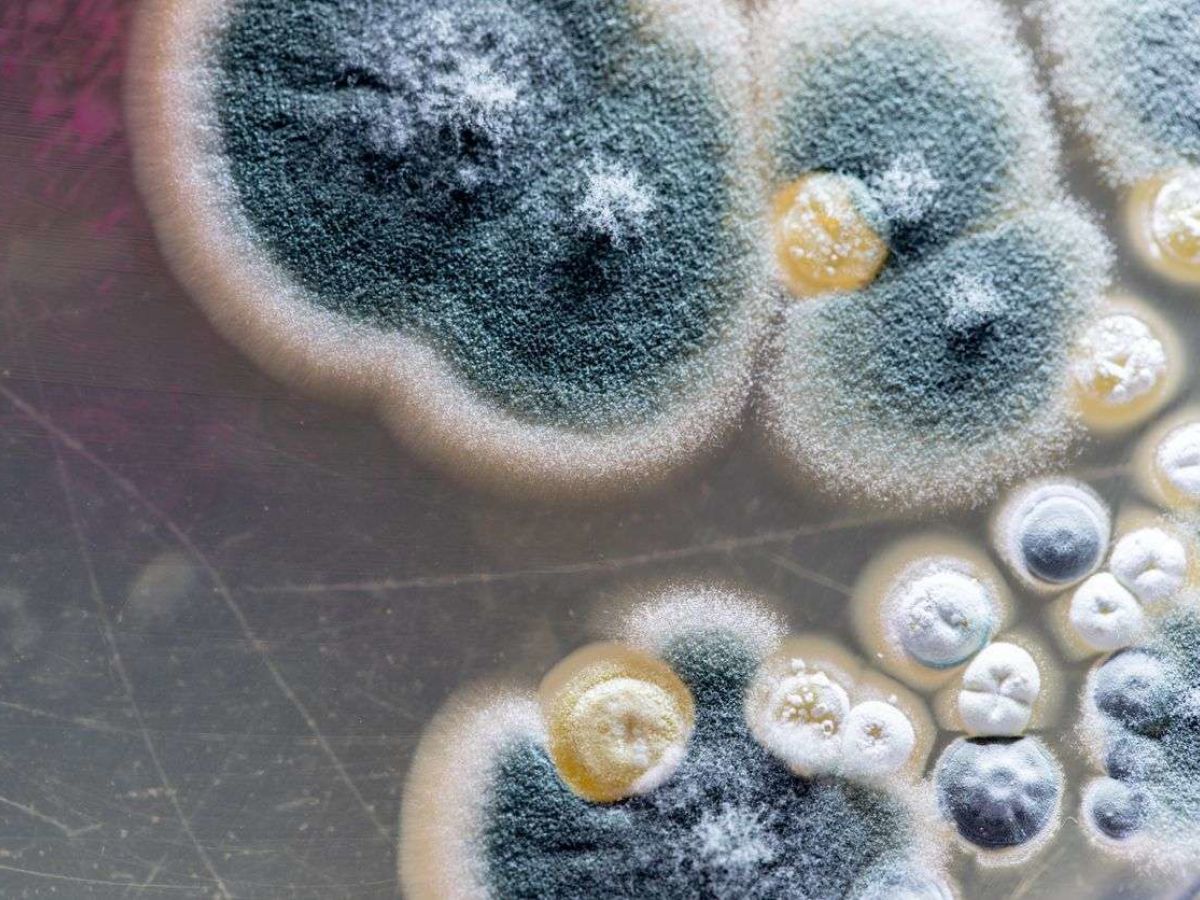

Primeiro caso de “fungo preto” após covid-19 é confirmado no Pará
A Secretaria de Estado de Saúde Pública (Sespa) confirmou nesta quinta-feira,10, o primeiro caso de mucormicose, nome real da doença, no Estado. Embora o caso tenha sido notificado em Conceição do Araguaia, o paciente é um idoso morador de Santana do Araguaia. Ele foi atendido com covid-19 no Hospital Regional de Conceição do Araguaia, onde teve melhora clínica e recebeu alta hospitalar.
Segundo a Sespa, entretando, “após alguns dias, teve piora e devido mal estar procurou por conta própria atendimento em Araguaína/Palmas, onde foi internado e recebeu o diagnóstico de Mucormicose, e foi transferido para tratamento em São Paulo”.
Por nota, Sespa informa que “investiga o caso para detecção do local provável de infecção e que realiza ações de orientação junto aos profissionais do hospital relacionadas às medidas sanitárias necessárias para evitar a transmissão intra-hospitalar deste fungo”.
Por fim, a Sespa “esclarece que a Murcomicose é uma infecção fúngica oportunista e não transmissível, sendo causada por ser que vive em meio ambiente em substratos orgânicos em decomposição”.




